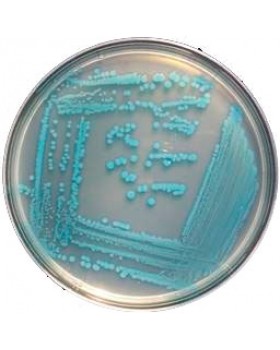
ПАЛ питательный агар для выделения листерий 0.25 кг ПАЛ питательный агар для выделения листерий 0.25 кг

нефрас 'Калоша' фас. 10 л.
-
- Производители ---
- Доступность: На складе
- Код товара: 4640
- Без НДС: По запросу
Химическая формула: Органическая смесь углеводородов
Нефрас (калоша) представляет собой бесцветную прозрачную жидкость, с запахом, схожим с бензиновым. Нефрас активно применяется в резиновой промышленности. Нефрас -отличное средство для разрежения краски, эмали. Также он используется для обезжиривания поверхностей, которые предназначены для склеивания. Возможно использования нефраса в качестве топлива для каталитических грелок. Рекомендуется его применять как топливо для бензиново-паяльных ламп. Примечательно, что нефрас нельзя использовать в качестве постоянного автомобильного топлива. Нефрас (калоша) активно используется в промышленности, где он незаменим.
Вы смотрели
Интересные факты
История бенгальских огней
- 23.01.2025
Бенгальские огни – это яркие атрибуты праздника, неразрывно...
Подробнее..Почему, когда вливаешь воду в стакан, она оказывается на столе?
- 23.01.2025
Вы, вероятно, замечали, как при наливании жидкости...
Подробнее..Что такое аналемма?
- 22.01.2025
Возможно, вы обращали внимание на старинных глобусах на таинственную...
Подробнее..Можете добавлять сколько угодно вкладок (табов), с любой информацией : текст, фото, видео и т.д.